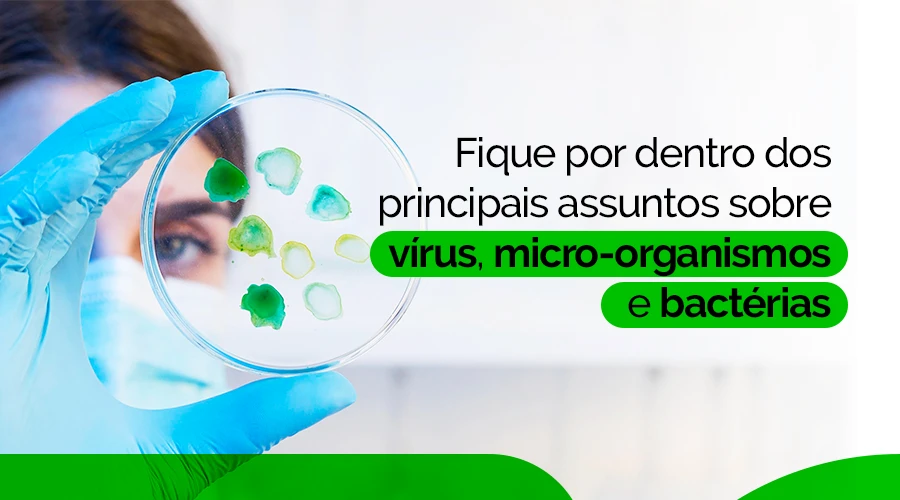

A entrada do Brasil noTratado de Budapeste representa um dos passos mais relevantes da última década para o avanço da biotecnologia, da pesquisa científica e da inovação em saúde pública.
Ao reconhecer oficialmente o Depósito Internacional de Micro-organismos para fins de patente, o país passa a integrar um grupo restrito de nações que simplificam e fortalecem a proteção intelectual de descobertas científicas envolvendo bactérias, vírus e fungos.
Essa medida estimula o desenvolvimento de soluções em segurança alimentar, saúde e controle microbiológico, abrindo caminho para novas tecnologias de prevenção e proteção antimicrobiana.

O que é o Tratado de Budapeste
O Tratado de Budapeste é um acordo internacional administrado pela Organização Mundial da Propriedade Intelectual (OMPI), criado para padronizar o Depósito de Micro-organismos para efeitos do procedimento em matéria de patentes.
Em termos práticos, ele permite que uma amostra biológica depositada em um único centro reconhecido internacionalmente tenha validade jurídica em todos os países signatários.
Isso significa que pesquisadores e empresas que desenvolvem micro-organismos com aplicação tecnológica, como cepas bacterianas, microrganismos modificados ou biodegradáveis, não precisam mais realizar múltiplos depósitos nacionais para garantir seus direitos de propriedade intelectual.
O ingresso brasileiro, formalizado pelo Decreto Legislativo n.º 48/2020 e recentemente ratificado pelo Congresso Nacional, foi detalhado pelo INPI e reconhecido como uma virada legal na biotecnologia nacional, segundo a Revista Cultivar.
Por que essa adesão é um divisor de águas para a pesquisa científica
A adesão ao tratado simplifica o processo de registro e proteção de patentes biotecnológicas, o que incentiva a pesquisa aplicada em diversas áreas, entre elas, a segurança antimicrobiana e o desenvolvimento de tecnologias preventivas.
Com a nova regulamentação, institutos de pesquisa e empresas de base tecnológica terão maior segurança jurídica para depositar e compartilhar micro-organismos desenvolvidos em laboratório. Isso tende a acelerar colaborações internacionais, ampliar investimentos e transformar descobertas científicas em produtos de impacto real na sociedade.
De acordo com a Interfarma, a entrada do Brasil no tratado favorece não apenas a inovação industrial, mas também a transferência de tecnologia e a formação de ambientes regulatórios mais modernos.

Patentes de micro-organismos e o impacto na segurança antimicrobiana
O registro formal de patentes de micro-organismos é essencial para proteger invenções que envolvem cepas com aplicação em medicamentos, cosméticos, saneantes, alimentos e superfícies com propriedades antimicrobianas.
Esses micro-organismos podem servir como base para novas tecnologias de proteção contra bactérias e vírus, reforçando a biossegurança e a sustentabilidade em diferentes setores.
A integração do Brasil ao Tratado de Budapeste permitirá que cientistas brasileiros depositem amostras com valor de pesquisa reconhecido em todo o mundo, fortalecendo o ecossistema de inovação microbiológica.
Isso cria um ambiente favorável para empresas especializadas em tecnologia antimicrobiana, que desenvolvem soluções aplicadas à segurança alimentar, à saúde pública e ao controle microbiológico de superfícies.
Pesquisa, biotecnologia e segurança alimentar
A biotecnologia moderna tem papel central na prevenção de infecções e na melhoria das condições sanitárias de ambientes industriais e coletivos.
Com a adesão ao tratado, o Brasil fortalece sua posição em estudos sobre bactérias resistentes, biofilmes e tecnologias de superfície ativa, que ajudam a impedir a aderência e a proliferação de micro-organismos.
Pesquisas voltadas à segurança alimentar e ao desenvolvimento de materiais antimicrobianos também se beneficiam diretamente da medida, uma vez que passam a ter maior proteção intelectual e visibilidade internacional.
Isso favorece o avanço de soluções inovadoras aplicáveis à cadeia de alimentos, embalagens, utensílios e sistemas de transporte, essenciais para reduzir riscos de contaminação e proteger a saúde pública.
O futuro da inovação científica no Brasil
A adesão ao Tratado de Budapeste cria uma base sólida para a internacionalização da pesquisa brasileira e a valorização de tecnologias com potencial de impacto global.
Com a simplificação dos processos de patenteamento e a ampliação do reconhecimento jurídico, o país ganha credibilidade científica e atrai investimentos privados e públicos.
O fortalecimento de uma cultura de proteção de descobertas biotecnológicas impulsiona setores estratégicos como o de saúde, agricultura, energia e saneamento, além de reforçar a importância da prevenção microbiológica e da inovação em segurança antimicrobiana.
Esse avanço consolida o Brasil como ator ativo em um cenário global de colaboração científica e sustentabilidade, em que ciência e tecnologia caminham lado a lado na proteção da vida.
Por que o Tratado de Budapeste é estratégico para a saúde e a inovação
Ao facilitar o depósito de micro-organismos para efeitos de patente, o tratado estimula o surgimento de novas descobertas sobre bactérias e vírus e viabiliza a aplicação prática dessas pesquisas em soluções de tecnologia antimicrobiana.
Esse é um passo essencial para a segurança alimentar, o controle de infecções hospitalares e a prevenção de futuras crises sanitárias, reforçando a importância de políticas que unam ciência, inovação e responsabilidade pública.

